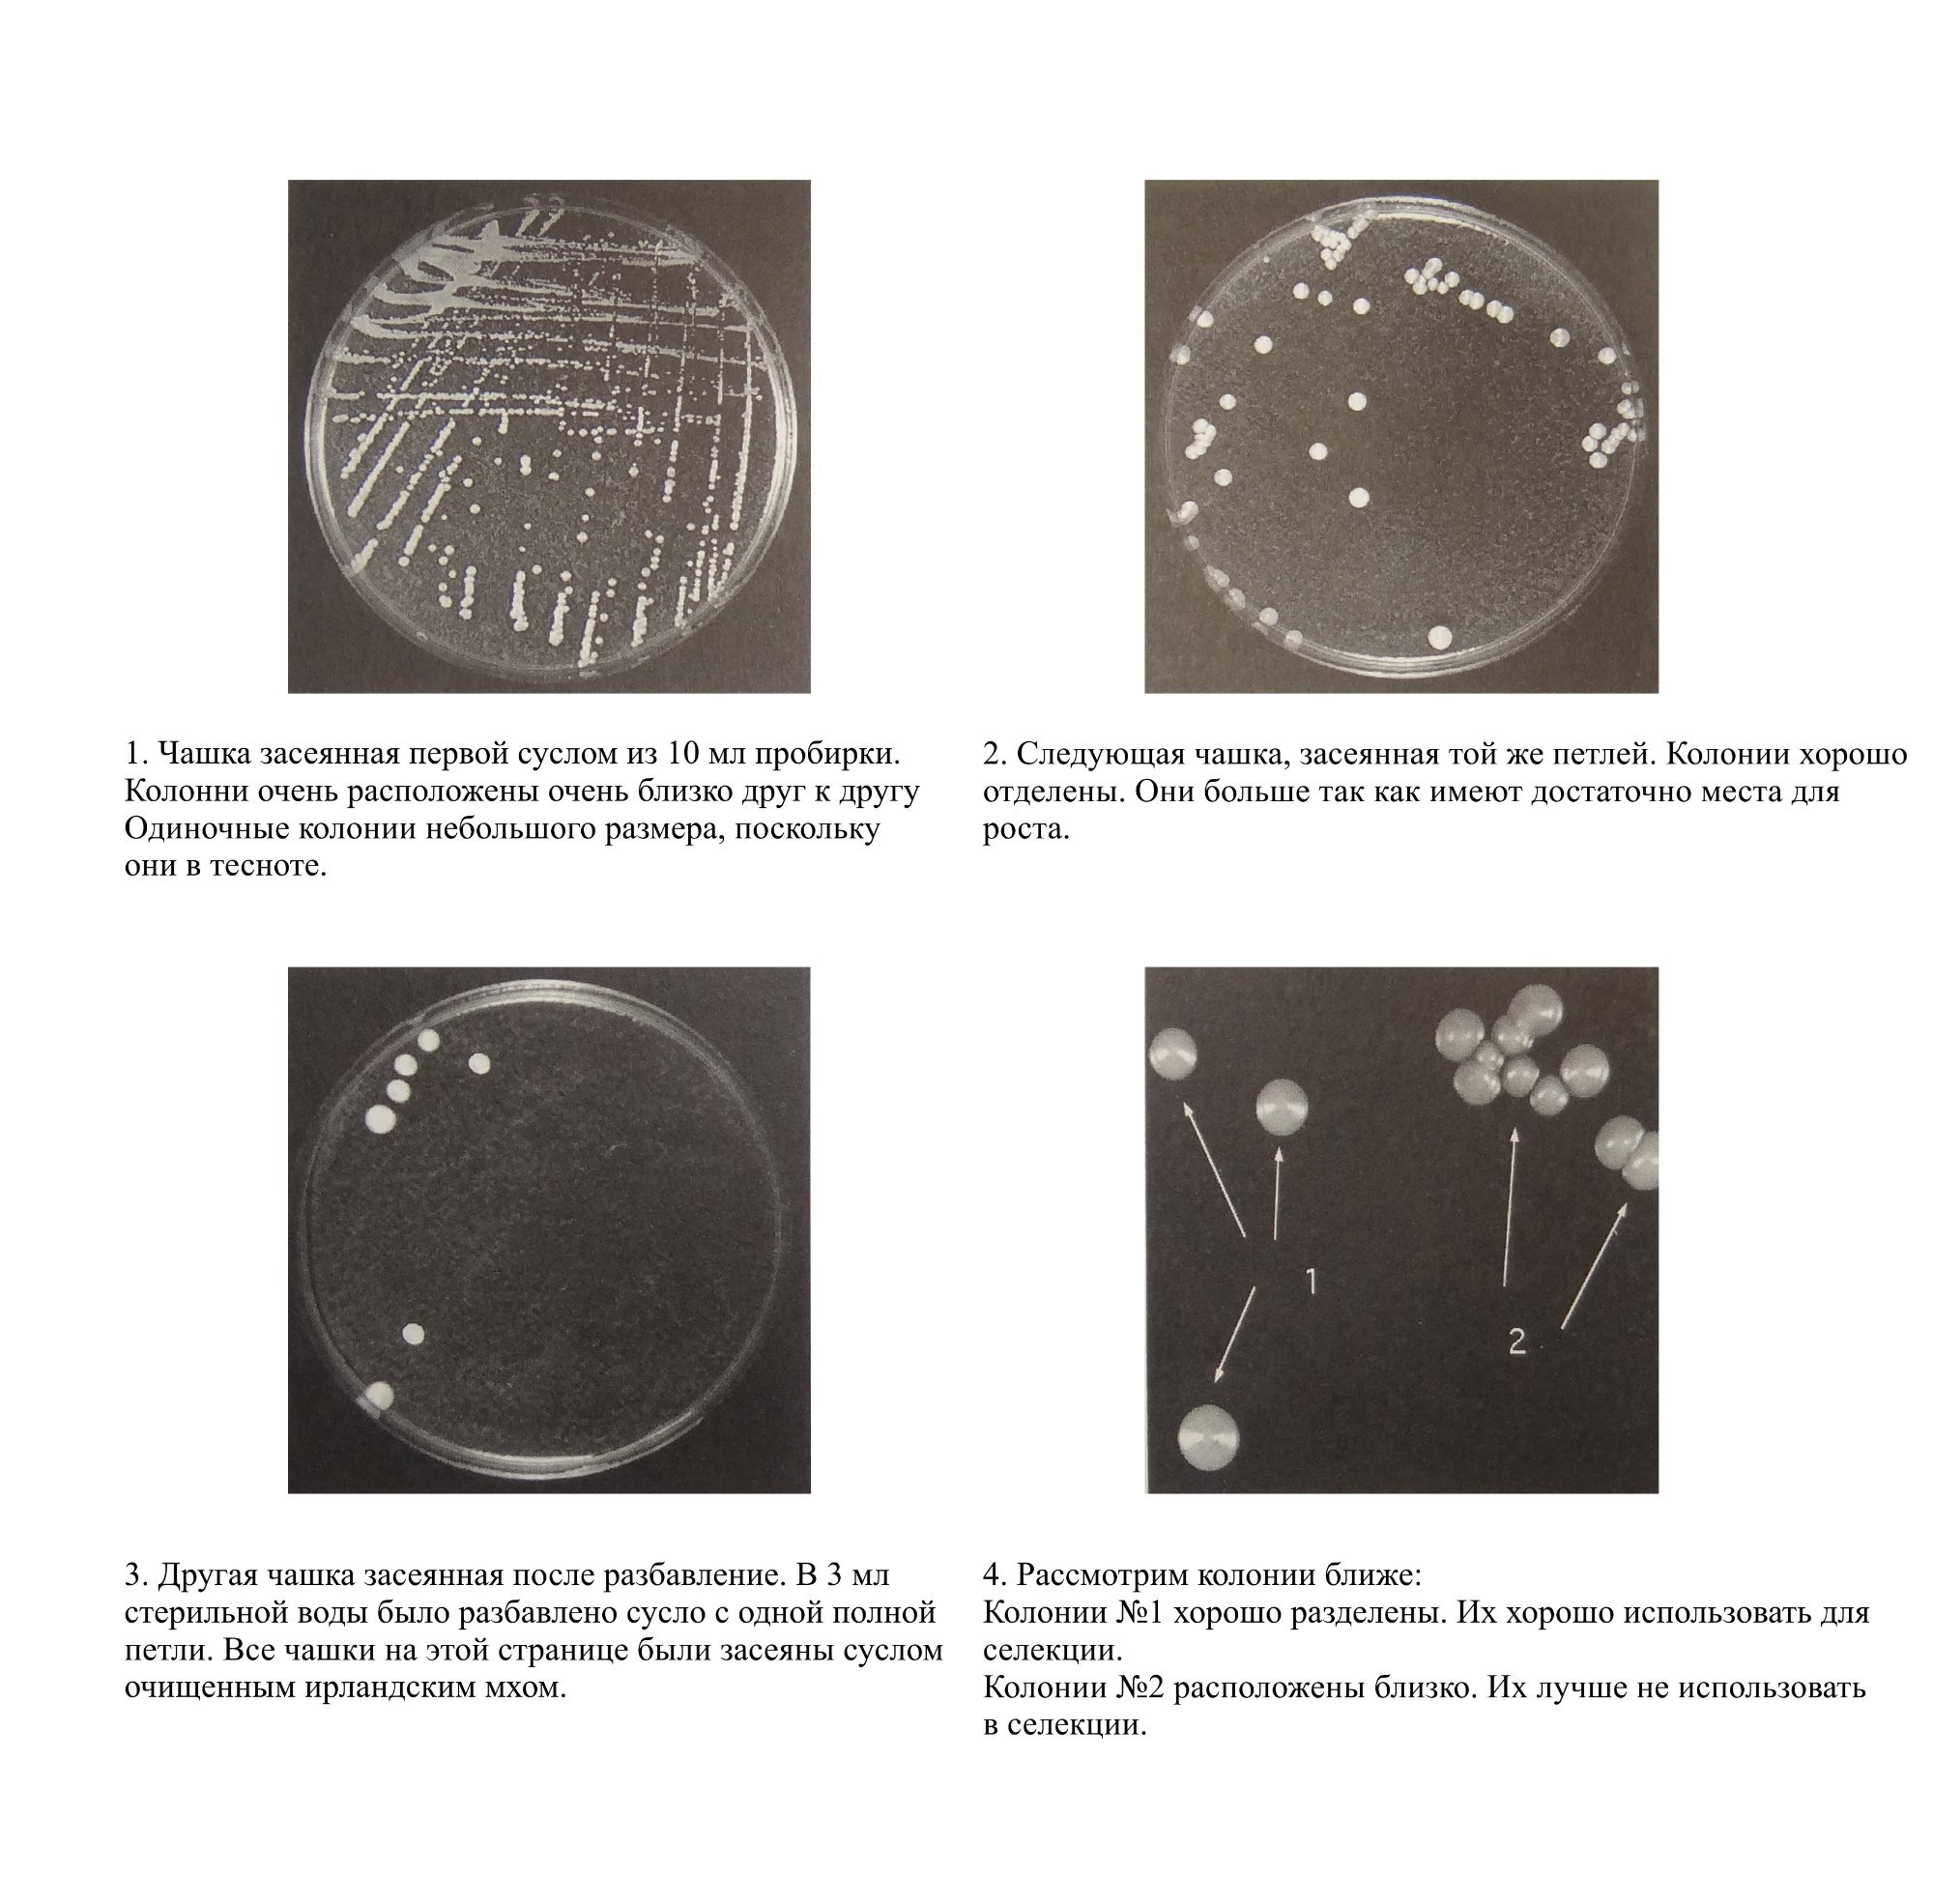

Засев чашек Петри
RomanBrewДля этого есть два метода. Взять образец петлей и разнести по поверхности. Или развести образец в стерильной воде, а потом разнести.
Первый метод дает высокую плотность колоний на чашке. Это выглядит как ковер из дрожжей. При этом трудно выбрать отдельную колонию.
Второй способ дает достаточное распределение с первого разнесения. Легко выбрать отдельную колонию. Результат обоих методов может быть одинаковым.
Возможно получить отдельные хорошо выраженные колонии без разбавления пробы. Для этого после первого разнесения возьмите следующую чашку и той же иглой (не берите новую пробу) разнесите еще раз затем повторите так же с третей чашкой.